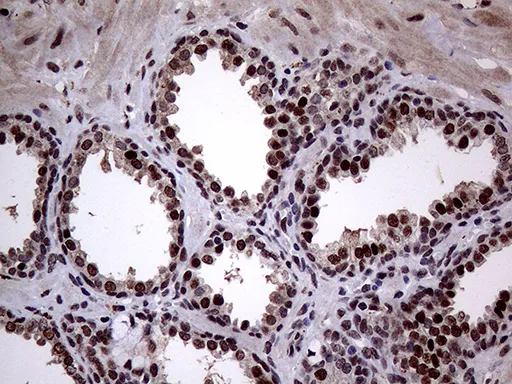

中文 | English

English
ANP32C mouse monoclonal antibody,clone OTI10A10
货号: GAM920724
ANP32C mouse monoclonal antibody,clone OTI10A10
反应种属:
Human
应用:
FCIHCWB
¥ 960
/ 50μl
库存充足
50μl100μl
产品详情
推荐稀释比
产品特性
反应种属
Human
应用
FCIHCWB
纯化方式
Affinity Purification
克隆号
OTI10A10
免疫源
Full length human recombinant protein of human ANP32C(NP_036535) produced in E.coli.
来源
Mouse
克隆性
Monoclonal
Background
Phosphoprotein 32 (PP32) is a tumor suppressor that can inhibit several types of cancers, including prostate and breast cancers. The protein encoded by this gene is one of at least two proteins that are similar in amino acid sequence to PP32 and are part of the same acidic nuclear phosphoprotein gene family. However, unlike PP32, the encoded protein is tumorigenic. The tumor suppressor function of PP32 has been localized to a 25 amino acid region that is divergent between PP32 and the protein encoded by this gene. This gene does not contain introns. [provided by RefSeq, Jul 2008]
预测分子量
26.6 kDa
Uniprot
O43423
Isotype
IgG2a
产品别名
ANP32C

货号: GAM920724
ANP32C mouse monoclonal antibody,clone OTI10A10
反应种属:
Human
应用:
FCIHCWB
¥ 960
/ 50μl
库存充足
50μl100μl
产品详情
推荐稀释比
产品特性
反应种属
Human
应用
FCIHCWB
纯化方式
Affinity Purification
克隆号
OTI10A10
免疫源
Full length human recombinant protein of human ANP32C(NP_036535) produced in E.coli.
来源
Mouse
克隆性
Monoclonal
Background
Phosphoprotein 32 (PP32) is a tumor suppressor that can inhibit several types of cancers, including prostate and breast cancers. The protein encoded by this gene is one of at least two proteins that are similar in amino acid sequence to PP32 and are part of the same acidic nuclear phosphoprotein gene family. However, unlike PP32, the encoded protein is tumorigenic. The tumor suppressor function of PP32 has been localized to a 25 amino acid region that is divergent between PP32 and the protein encoded by this gene. This gene does not contain introns. [provided by RefSeq, Jul 2008]
预测分子量
26.6 kDa
Uniprot
O43423
Isotype
IgG2a
产品别名
ANP32C

扫码添加微信客服
